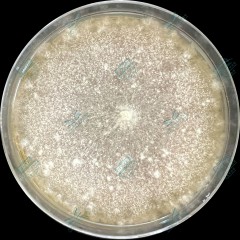
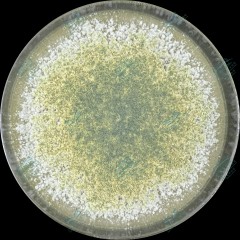
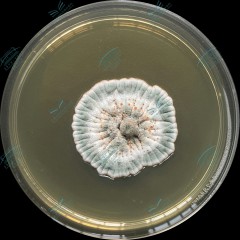
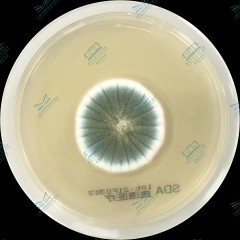
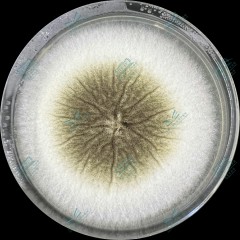
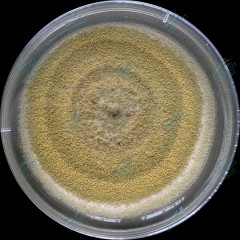

枝孢样枝孢霉 Cladosporium cladosporioides 病原分类地位:半知菌亚门,丝孢菌纲,暗色孢科,枝孢霉属。 博物馆文物展陈环境及文物本体的常见污染菌,主要对木质、纸质、石质文物造成危害。该菌株在沙氏葡萄糖琼脂培养基上菌落呈橄榄绿色,反面黑绿色,平铺,气生菌丝色暗。分生孢子顶生或侧生,形成分枝的孢子链,椭圆形、柠檬型、近球形,无隔平滑。
-

霉图库-枝孢样枝孢霉
-

霉图库-球毛壳
球毛壳 Chaetomium globosum 病原分类地位:子囊菌亚门、核菌纲、粪壳菌目,毛壳菌科,毛壳属。 广泛分布于自然界中含纤维素的各种基质上,可有效降解纤维素和木质素等难降解的大分子有机物,环境适应能力强,生长迅速。该菌株在沙氏葡萄糖琼脂培养基上气生菌丝呈浅黄色至橄榄色,有固定的孔口,子囊果不埋生,球形至椭圆形外。子囊果顶生附属丝密生,褐色,直或弯曲;子囊孢子成熟时呈浅褐色,内含多个油滴,柠檬型,两侧平滑,两头稍尖突起,有单个顶生萌发孔。
-

霉图库-长枝木霉
长枝木霉 Trichoderma longibrachiatum 病原分类地位:半知菌亚门,丝孢纲,丝孢目,丛梗孢科,木霉属。 该菌株在沙氏葡萄糖琼脂培养基上菌落初期菌丝白色,生长迅速,继续生长产生分生孢子,分生孢子绿色,以接种点为圆心呈同心纹状分布。分生孢子椭圆形或细长椭圆形,光滑;典型的分生孢子梗包括发育强壮的中轴,在中轴上向顶端产生单生的瓶梗,随着离顶端距离的延伸,产生成对的长度逐渐增加的二次分枝;瓶梗直接着生在二次分枝上。瓶梗主要为单生,典型形状为圆柱形,呈涡状排列时中间部分膨大,直或弯
-

霉图库-橘青霉
橘青霉 Penicillium citrinum 病原分类地位:子囊菌亚门,丝孢纲,丝孢目,丛梗孢科,青霉属。 该菌株在沙氏葡萄糖琼脂培养基上菌落质地通常绒状或中心带絮状,具大量放射状皱纹,菌落常呈现典型的蓝绿色或灰绿色,有淡黄色、黄色的渗出液滴。帚状枝通常由3一5个不同程度叉开的梗基组成,充分成熟的梗基顶端膨大成囊状,分生孢子结构大量产生。
-

霉图库-产红青霉
产红青霉 Penicillium rubens 病原分类地位:子囊菌亚门,丝孢纲,丝孢目,丛梗孢科,青霉属。 从炎热的赤道到寒冷的南极的土壤、大气中和其他各种基物上都有存在青霉属的可能,因产生许多有益的代谢产物如青霉素被人们所利用,或因有害而受到人们的遏制。它能毁坏各种织物、皮革、档案及图书等,是文物来源的常见污染菌。该菌株在沙氏葡萄糖琼脂培养基上菌落致密绒毛状,表面有规则放射状沟纹,呈灰绿色,边缘白色。帚状枝两轮生或三轮生,偶有四轮生,常具有副枝1-2个 ,分生孢子近球形或椭圆形。
-

霉库图-黑曲霉
黑曲霉 Aspergillus niger 病原分类地位:子囊菌亚门,丝孢纲,丝孢目,丛梗孢科,曲霉属真菌中的一个常见种。 该菌株在沙氏葡萄糖琼脂培养基上菌落表面呈暗褐黑色至炭黑色,具辐射状沟纹,质地丝绒状或稍呈絮状,菌落反面呈不同程度的黄色。顶囊球形或近球形,产孢结构双层,有不同程度粗糙的分生孢子。
-

霉图库-黄曲霉
黄曲霉 Aspergillus flavus 病原分类地位:子囊菌亚门,丝孢纲,丝孢目,丛梗孢科,曲霉属。 曲霉属是自然界分布最普遍的腐生菌类之一,几乎是到处存在。由于曲霉产生大量的孢子和具有多种多样的生化活性,使它们能在不同环境和基物上生长。该菌株在沙氏葡萄糖琼脂培养基上菌落质地丝绒状,颜色为黄绿色至草绿色,初期较淡,老后稍深。分生孢子头初为球形,后呈辐射型,顶囊近球形至烧瓶型,分生孢子具有细密的小刺。
-

虫图库-花斑皮蠹
学名:花斑皮蠹 拉丁名:Trogoderma variabile 分类地位:动物界、节肢动物门、昆虫纲、鞘翅目、皮蠹科 形态特征:体长约3毫米,卵圆形,赤褐色至深褐色,着生黄褐色、白色细毛。触角11节,棒状,棒节逐渐变粗,长可达前胸背板基部。前胸背板两侧圆,向前端呈弧形,后缘中间突出,两侧刻点密于顶区。鞘翅具褐色与暗红色环状纹与花斑,有时不完全或不明显,覆短而稀疏的毛。 生活习性:此虫一般每年1~2代,老熟幼虫越冬,耐饥性强。成虫将卵散产于板缝、图书、档案的纸缝中。发育历期卵,幼虫,蛹和成虫,在